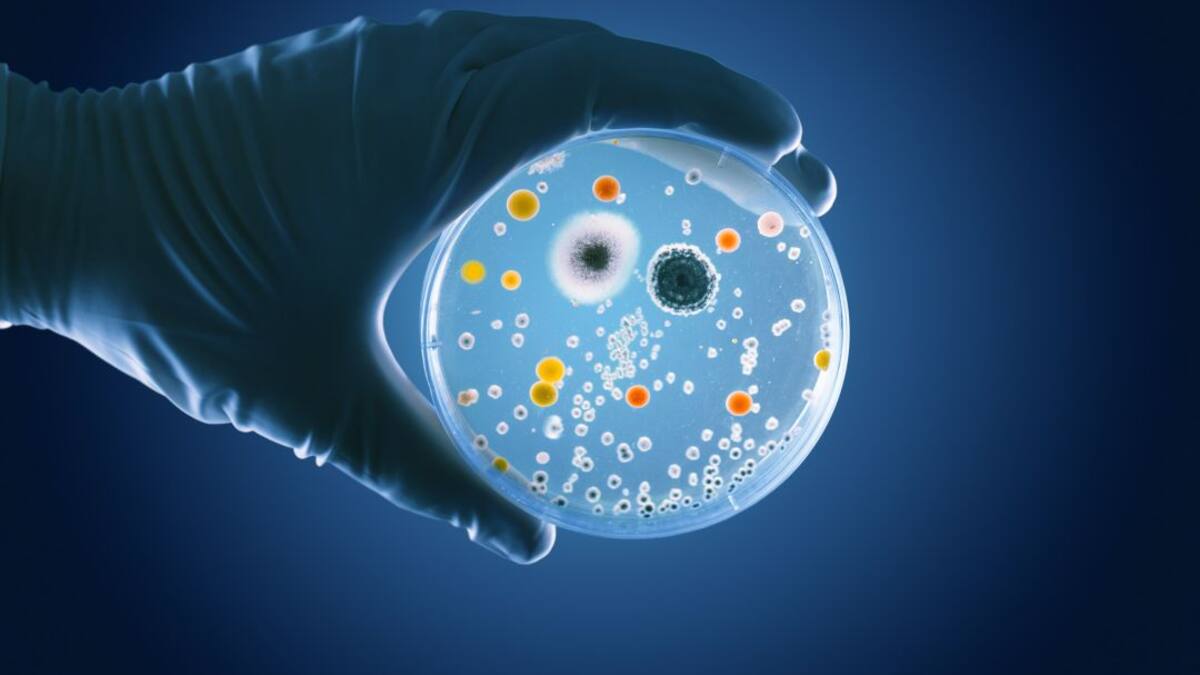
¿Por qué la covid-19 puede causar diarreas y vómitos?

The Conversation
13/08/2021
12/08/2021
11/08/2021
10/08/2021

Qué es la nueva pornografía y cómo la consumen los más jóvenes
La nueva pornografía se podría caracterizar por filmaciones de sexo explícito, con acceso fácil, distribución mediante internet masivamente gratuita, alta calidad, orientadas a generar excitación sexual
10/08/2021 - 09:42
The Conversation
09/08/2021

Informe IPCC: por qué el cambio climático causa tormentas e inundaciones más intensas
Este pasado mes de julio ha dejado imágenes por todo el mundo de fuertes inundaciones a un nivel más extremo de lo normal
09/08/2021 - 16:18
The Conversation
Madrid
06/08/2021
05/08/2021
04/08/2021

¡Alerta, micotoxinas! Se acabó lo de quitar solo la parte con moho de los alimentos
Cuando almacenamos los alimentos en condiciones inadecuadas, empiezan a crecer sobre ellos y algunos pueden producir micotoxinas, unos compuestos que afectan gravemente la salud humana y animal
04/08/2021 - 11:45
The Conversation
03/08/2021
02/08/2021

¿Para cuándo el fin de la pandemia? El peligro de las nuevas variantes
La razón fundamental por la que la pesadilla continúa radica en un hecho clave: no se ha frenado la transmisión
02/08/2021 - 12:50
The Conversation
Málaga